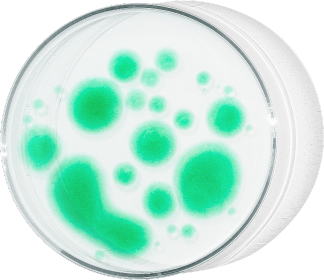

lima bajo el microscopio

Lima bajo el microscopio
¿Cuántas bacterias hay en lo que tocas?





El Comercio y la Pontificia Universidad Católica del Perú realizaron un análisis microbiológico en 12 puntos de Lima Metropolitana, el cual confirmó que muchas superficies de uso común en la capital presentan niveles de microorganismos que superan los límites permitidos por normativas sanitarias.
Las superficies pueden albergar microorganismos capaces de transmitir enfermedades. Sin darnos cuenta, podemos sujetarnos de una baranda contaminada con bacterias o permanecer en un paradero donde el aire contiene moho. En una escalera del mercado central, por ejemplo, se encontraron niveles de coliformes seis veces superiores a los límites establecidos por Digesa.
Eliminar por completo las bacterias de nuestro entorno es imposible, pero podemos controlarlas para minimizar los riesgos.
pero primero, un test

1. ¿Tocaste alguna de estas superficies en las últimas horas?

2. ¿Cuántas veces te lavaste hoy las manos?

3. ¿Has sufrido alguna de estas enfermedades en los últimos meses?
Lavarse las manos es crucial porque previene la propagación de gérmenes, protegiendo tanto al individuo como a la comunidad de enfermedades como resfriados, gripe, diarrea y neumonía.


¿Cómo hicimos el estudio?
12
superficies públicas evaluadas







Esta investigación fue realizada por el Laboratorio de Ingeniería Médica de la PUCP. Con el apoyo de un equipo de periodistas de El Comercio que documentó todo el proceso, biólogos especializados tomaron muestras en 12 espacios públicos utilizando hisópos estériles.


Este material fue sometido a pruebas de laboratorio con reactivos especiales para hallar bacterias coliformes y hongos.
¿Por qué lo hicimos?
Convivimos a diario con bacterias, virus y otros microorganismos potencialmente peligrosos, pero mientras cumplamos con medidas de higiene básicas, podremos estar protegidos.
Los hallazgos
¿Qué bacterias se encontraron y dónde?
Elige una escena para descubrir qué microorganismos y en qué cantidad encontró el Laboratorio de Ingeniería Médica de la PUCP.
baranda de
escalera

parque infantil

transporte
público

bandeja del patio de comidas

paradero

espacio
público

Caso 1: Baranda de escalera


La toma de muestras se realizó en una escalera de las galerías del Mercado Central. Con esto se pudo identificar que esta superficie tenía 60ufc/cm2 de coliformes, pero el máximo permitido es 10 ufc/cm2.
Coliformes
Son bacterias indicadoras de contaminación microbiológica, especialmente fecal.
6
veces más de lo permitido
para superficies en contacto con comidas y bebidas.
¿Qué podría pasar?
La presencia de coliformes en superficies de contacto frecuente puede representar un riesgo sanitario, ya que pueden causar infecciones gastrointestinales si ingresan al organismo a través de alimentos o contacto con mucosas. La reacción de nuestro organismo a estos agentes patógenos depende de el estado de nuestro sistema inmune.
“Convivimos a diario con microorganismos. Cuando el sistema inmune se encuentra estable, puede protegernos de infecciones causadas por virus o bacterias. Sin embargo, un sistema inmune con poca eficiencia puede no evitar una enfermedad”.

Fanny Casado Peña Profesora principal de Bioingeniería de PUCP.
Caso 2: Parque infantil


En la zona de juegos infantiles de un parque de Breña se detectó una alta presencia de coliformes totales, con un recuento de 57 UFC/cm², lo que indica contaminación microbiológica y un posible riesgo sanitario para los niños que usan estas instalaciones.
¿Qué podría pasar?
La presencia de coliformes en superficies de contacto frecuente puede representar un riesgo sanitario si ingresan al organismo a través de alimentos o contacto con mucosas.
“Convivimos a diario con microorganismos. Cuando el sistema inmune se encuentra estable, puede protegernos de infecciones causadas por virus o bacterias. Sin embargo, un sistema inmune con poca eficiencia puede no evitar una enfermedad”.

Fanny Casado Peña Profesora principal de Bioingeniería de PUCP.
Caso 3: Transporte público


En el pasamanos de un bus de la ruta Breña - San Martín de Porres se detectó la presencia de coliformes totales, con un recuento de 11 UFC/cm², evidenciando contaminación microbiológica.
¿Qué podría pasar?
La presencia de coliformes en superficies de contacto frecuente puede representar un riesgo sanitario si ingresan al organismo a través de alimentos o contacto con mucosas.
“Convivimos a diario con microorganismos. Cuando el sistema inmune se encuentra estable, puede protegernos de infecciones causadas por virus o bacterias. Sin embargo, un sistema inmune con poca eficiencia puede no evitar una enfermedad”.

Fanny Casado Peña Profesora principal de Bioingeniería de PUCP.
Caso 4: Bandeja del patio de comidas


La evaluación en una bandeja de un patio de comidas en Jesús María detectó coliformes totales con un recuento de 52 UFC/cm², superando los límites permisibles para superficies en contacto con alimentos (10 UFC/CM2, según norma de la Digesa).
Además, se detectaron 1100 ufc/m³ de mohos y levaduras en el aire, lo que advierte posible contaminación. Esta cifra excede los estándares internacionales. La OMS considera como carga “alta” a entre 500 y 2000 ufc/m³ y carga “muy alta” si es superior a 2000 ufc/m³.
¿Qué podría pasar?
La presencia de coliformes en superficies de contacto frecuente puede representar un riesgo sanitario si ingresan al organismo a través de alimentos o contacto con mucosas.
“Convivimos a diario con microorganismos. Cuando el sistema inmune se encuentra estable, puede protegernos de infecciones causadas por virus o bacterias. Sin embargo, un sistema inmune con poca eficiencia puede no evitar una enfermedad”.

Hammerly Lino Fuentes Rivera Jefe de práctica de la carrera de Ingeniería Ambiental de la PUCP
Caso 5: Paradero


En el paradero de autobuses frente al Hospital del Niño, en el distrito de Breña, se detectó una alta concentración de mohos y levaduras en el aire, con un recuento de 1309 ufc/m³, lo que indica una contaminación microbiológica significativa en esa zona.
Esta cifra excede los estándares internacionales de calidad del aire. La OMS considera como carga “alta” a entre 500 y 2000 ufc/m³ y carga “muy alta” si es superior a 2000 ufc/m³.
¿Qué podría pasar?
La presencia de coliformes en superficies de contacto frecuente puede representar un riesgo sanitario si ingresan al organismo a través de alimentos o contacto con mucosas.
Caso 6: Espacio público


En la Plaza San Martín, en el centro de Lima, se detectó una alta concentración de mohos y levaduras en el aire, con un recuento de 2305 ufc/m³, el más alto del estudio.
¿Qué podría pasar?
La presencia de coliformes en superficies de contacto frecuente puede representar un riesgo sanitario si ingresan al organismo a través de alimentos o contacto con mucosas.
persona sana vs
persona inmunocomprometida
persona sana
Un sistema inmunológico saludable combate bacterias con barreras físicas como la piel y mucosas, ácidos gástricos que destruyen microorganismos.
También existen las células inmunitarias como macrófagos y linfocitos, que atacan patógenos para neutralizar infecciones antes de que se propaguen.
De esta forma, el contacto diario con virus, hongos o bacterias, presentes en muchos espacios, pasa desapercibido por el individuo.
persona
inmunocomprometida
Un sistema inmunológico debilitado por enfermedades o tratamientos médicos es más vulnerable a infecciones causadas por bacterias, virus y hongos.
Incluye a pacientes con cáncer, diabetes, con trasplantes de órganos o con tratamientos como quimioterapia o inmunosupresores.
Los niños y adultos mayores están en el grupo más propenso a contraer enfermedades porque su sistema inmune está en desarrollo o debilitado por la edad.

La importancia de lavarse las manos
Los microorganismos están en todo lo que tocamos. No es posible evadirlos, pero sí evitar que nos afecten con medidas simples de higiene como el correcto lavado de manos, el cuidado para estornudar y la limpieza regular de las superficies que tocamos.

